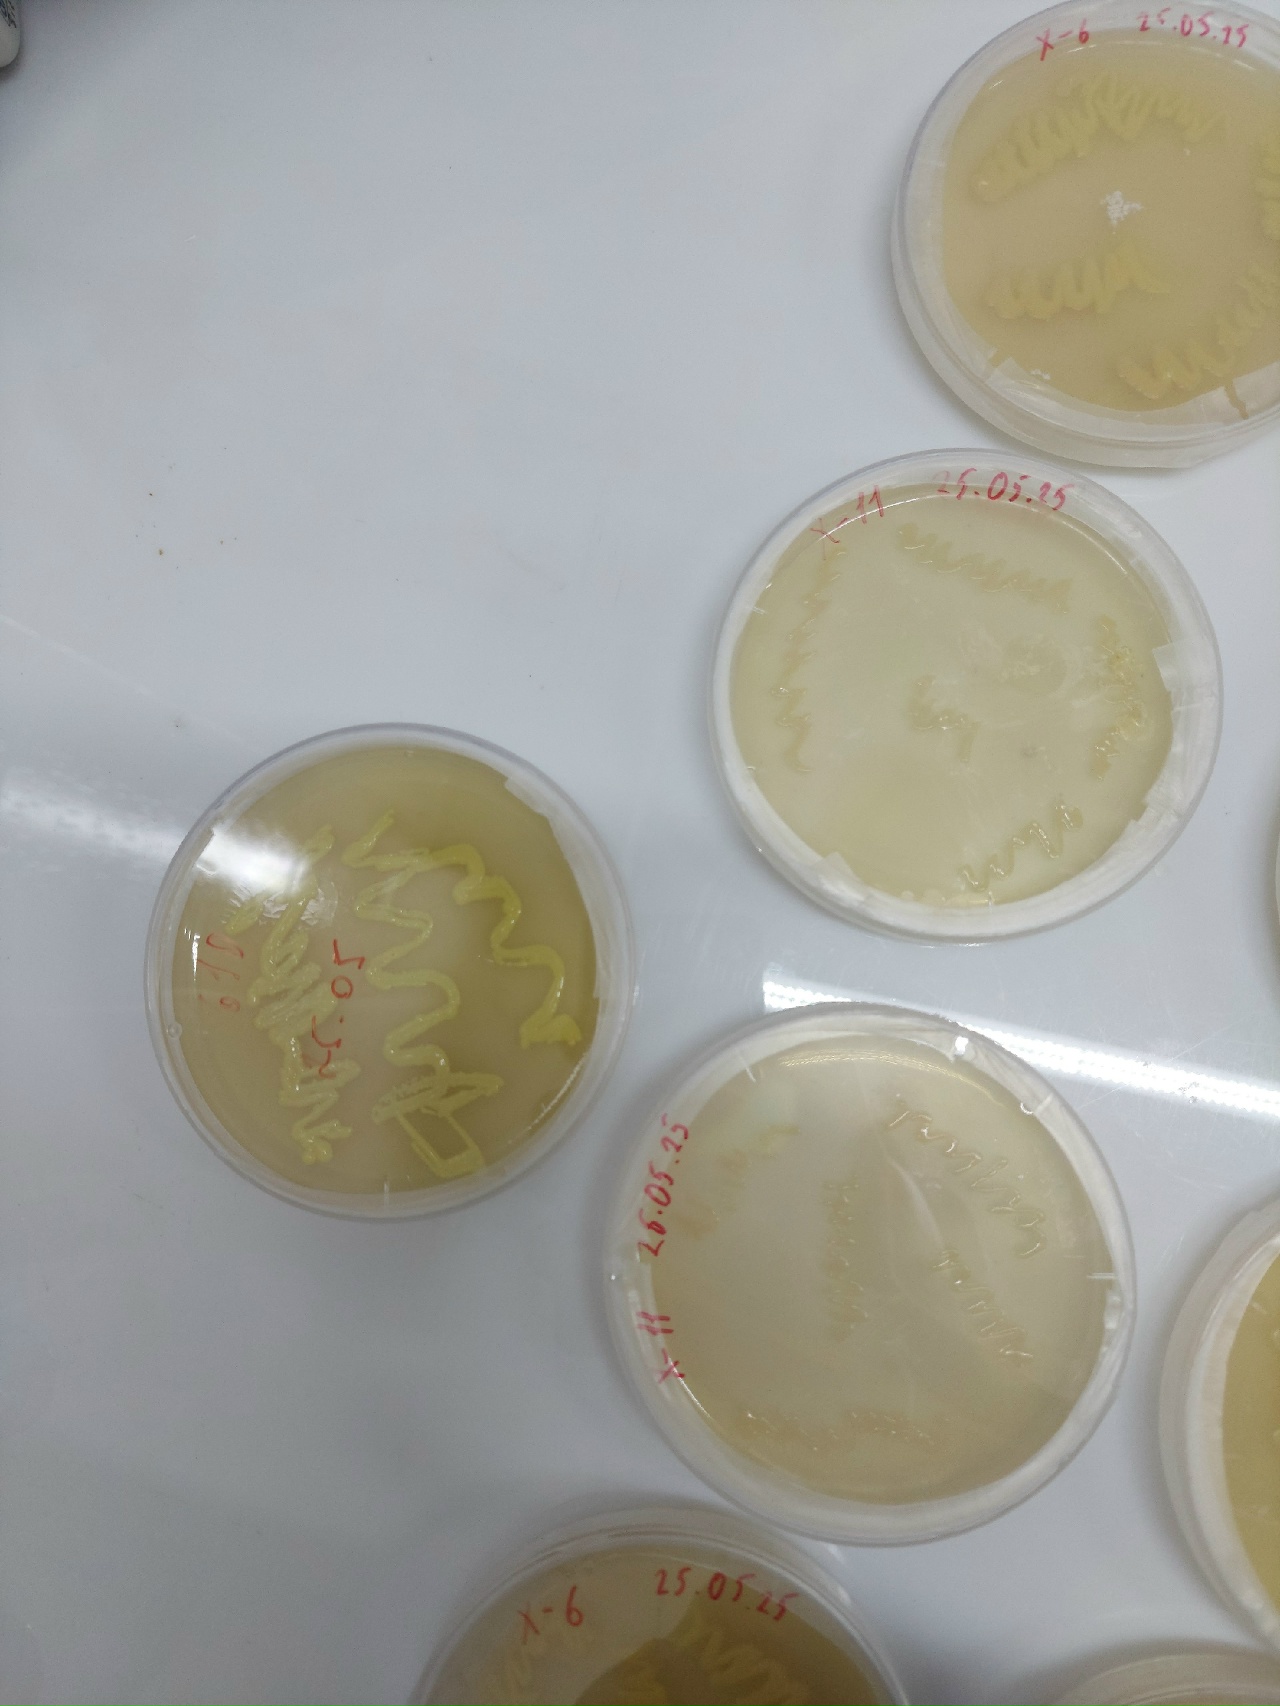
чашки петри с культурой бактерий Xanthomonas campestris
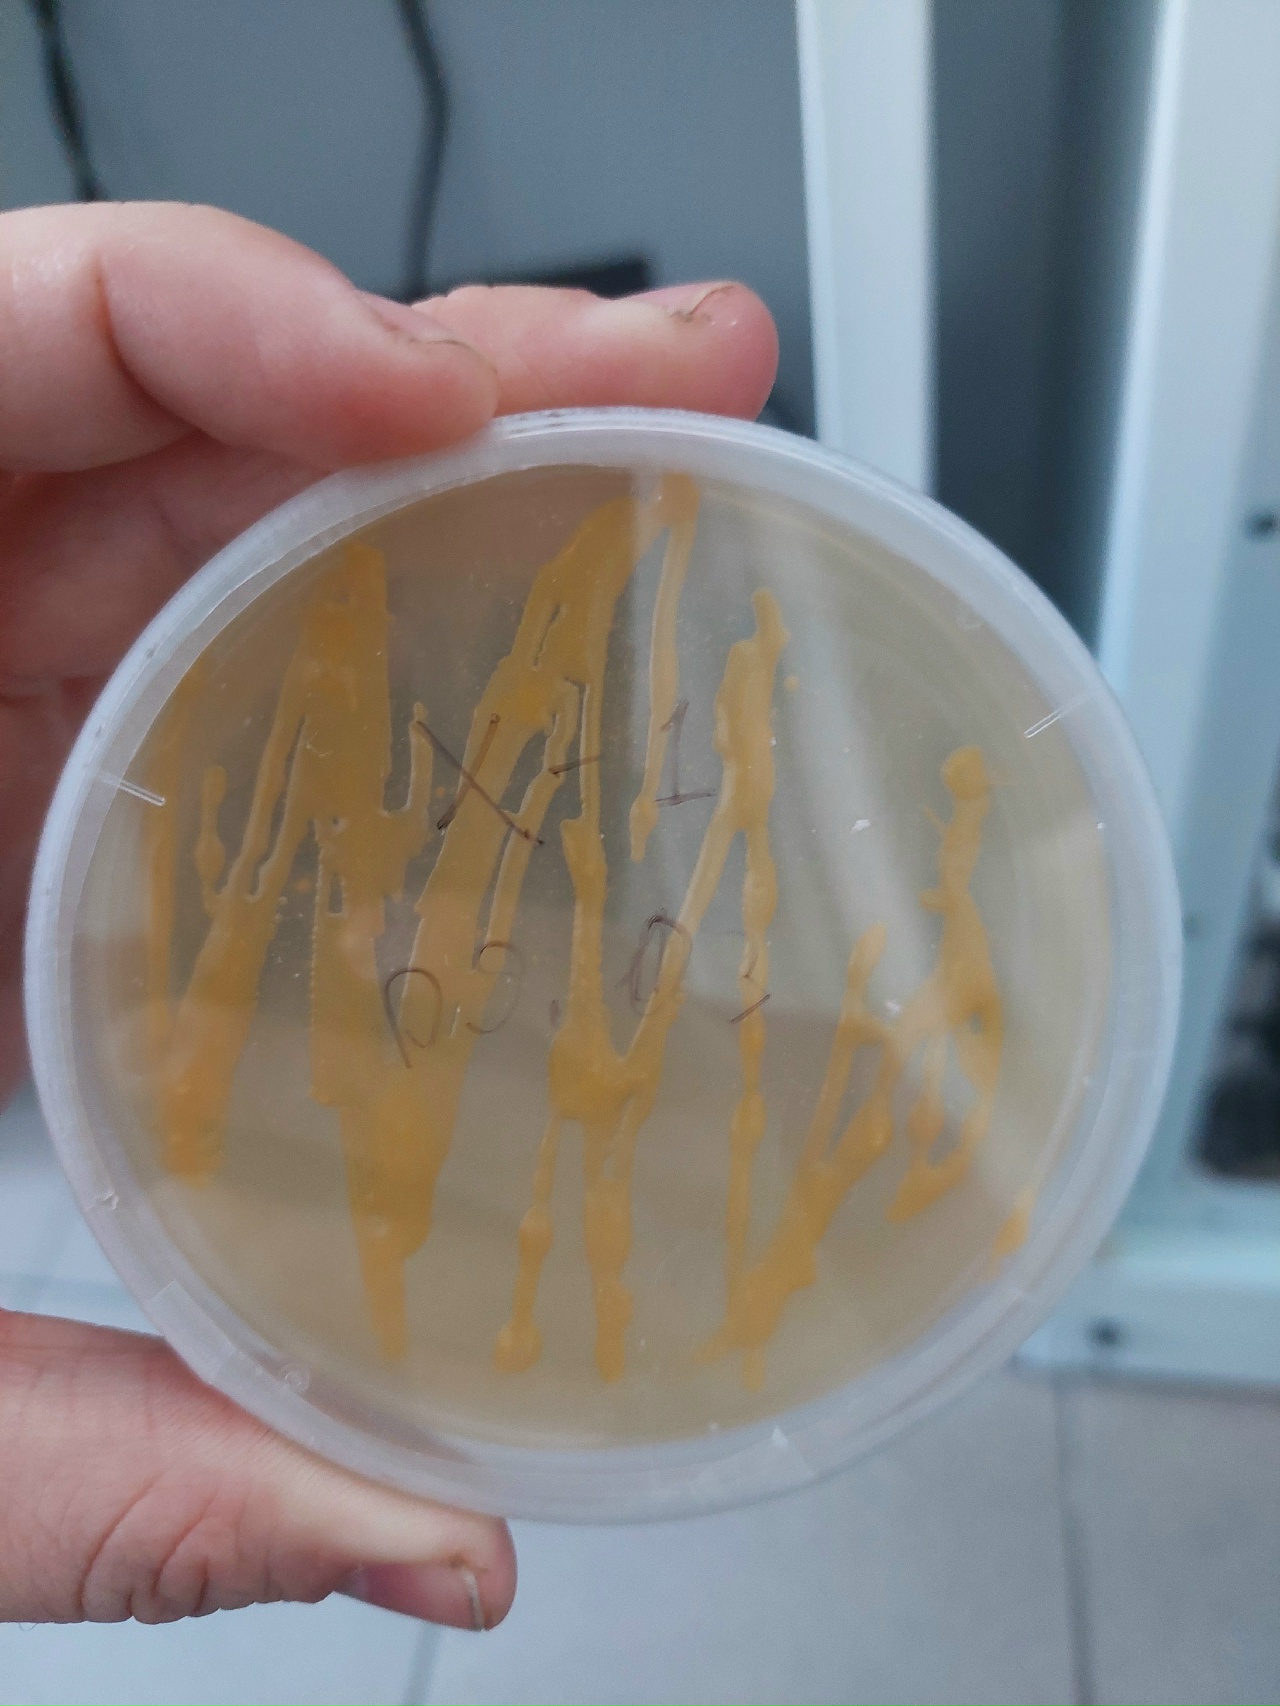
образец изолята Xanthomonas campestris

ООО «КСАН»
Наша компания ООО «КСАН» предлагает Ксантановую камедь – жизненно важный полимер для пищевой, нефтегазовой, фармацевтической и косметической промышленности. На сегодняшний день 100% ксантана в России – импортное, что создает риски для стратегических отраслей. Новый, высокоэффективный изолят бактерии Xanthomonas campestris представляет собой штамм, обладающий улучшенными характеристиками по сравнению с ранее известными изолятами. Эта бактерия широко используется в биотехнологии благодаря своей способности продуцировать ряд ценных соединений, включая биополимеры, ферменты и биологически активные вещества.
Важнейшие характеристики нового изолята
- Повышенная продуктивность: Новый изолят демонстрирует значительно большую способность к синтезу целевых продуктов, таких как ксантана (полисахарид, используемый в пищевой промышленности и косметологии).
- Устойчивость к стрессовым условиям: Изолят обладает повышенной устойчивостью к изменениям температуры, pH и осмотического давления, что позволяет использовать его в широком диапазоне условий культивирования.
- Генетическая стабильность: Штамм сохраняет свою генетическую структуру даже после многократных пассажей, что гарантирует стабильное производство целевого продукта.
- Биологическая безопасность: Изолят соответствует требованиям биологической безопасности и может использоваться в промышленных масштабах без риска для окружающей среды и здоровья человека.
Применение
- Пищевая промышленность: Ксантан, производимый новым изолятом, используется в качестве загустителя и стабилизатора в продуктах питания.
- Косметология: Биополимеры, полученные из бактерий, применяются в производстве кремов, шампуней и других косметических средств.
- Фармацевтика: Ферменты и биологически активные вещества, вырабатываемые бактериями, используются в разработке лекарственных препаратов.
Таким образом, новый, высокоэффективный изолят бактерии Xanthomonas campestris является перспективным инструментом для развития биотехнологических процессов и производства широкого спектра продукции.
Основные приемущества нашего продукта
Мы предлагаем готовое решение – новый, высокоэффективный изолят бактерии Xanthomonas campestris, позволяющий запустить рентабельное отечественное производство ксантановой камеди.
- 1. Продуктивность на 20% выше аналогов из Всероссийской коллекции промышленных микроорганизмов (ВКПМ).
- 2. Полностью охарактеризован и адаптирован для промышленного культивирования.
- 3. Готов к передаче лицензионным партнерам.
Чашки Петри с культурой бактерий Xanthomonas campestris
Ключевые характеристики изолята:
Чашка Петри с культурой бактерий Xanthomonas campestris
Наш штамм Xanthomonas campestris является результатом целенаправленных научных исследований, включающих сбор образцов, селекцию, выделение чистой культуры и всестороннее тестирование.
- 1. Продуктивность по ксантановой камеди не менее чем на 20% выше, чем у эталонных штаммов из коллекции ВКПМ.
- 2. Изучены морфологические, генетические и биохимические свойства. Проведено секвенирование для подтверждения видовой принадлежности.
-
3. Разработана эффективная методика культивирования, включающая:
- – Оптимальный температурный режим и уровень pH.
- – Состав питательной среды для максимального выхода продукта.
- – Протоколы для стимуляции продукции камеди.
О нас
Проект выполнен при поддержке «Фонда содействия инновациям» в рамках программы «Студенческий стартап» федерального проекта «Платформа университетского технологического предпринимательства»

Работа с изолятом бактерии Xanthomonas campestris
Наши реквизиты
Общество с ограниченной ответственностью ООО «КСАН»
Название: ООО «КСАН»
Юридический адрес: Алтайский край, Ключевский р-н, с. Северка, ул. Юбилейная д. 5., кв. 1.ИНН / КПП: 2248006026 / 224801001
ОГРН: 1242200016960
Готовы обсудить приобретение изолята или лицензионное соглашение?
Мы открыты для сотрудничества с промышленными партнерами, заинтересованными в организации собственного производства ксантановой камеди.
По вопросам приобретения и сотрудничества обращайтесь:
ФИО: Панкратов Сергей Юрьевич
Email: Написать письмо
Телефон: 8–913–230–27–92
Местонахождение: Алтайский край, Ключевский р-н, с. Северка, ул. Юбилейная д.5., кв. 1.